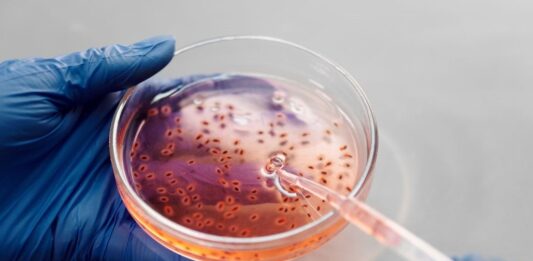

Elevación de la TEMPERATURA AMENAZA el PLANETA con MÁS PANDEMIAS (ENFERMEDADES)
Las olas de calor que azotaron a Estados Unidos y Europa batieron récords superiores a 40 grados en cientos de ciudades, mientras en el Cono Sur, grandes urbes como Buenos Aires registraron más de 25 grados en pleno invierno. Este escenario muestra una marca inequívoca sobre el calentamiento global que la Tierra sufre hoy. Los … Sigue leyendo Elevación de la TEMPERATURA AMENAZA el PLANETA con MÁS PANDEMIAS (ENFERMEDADES)